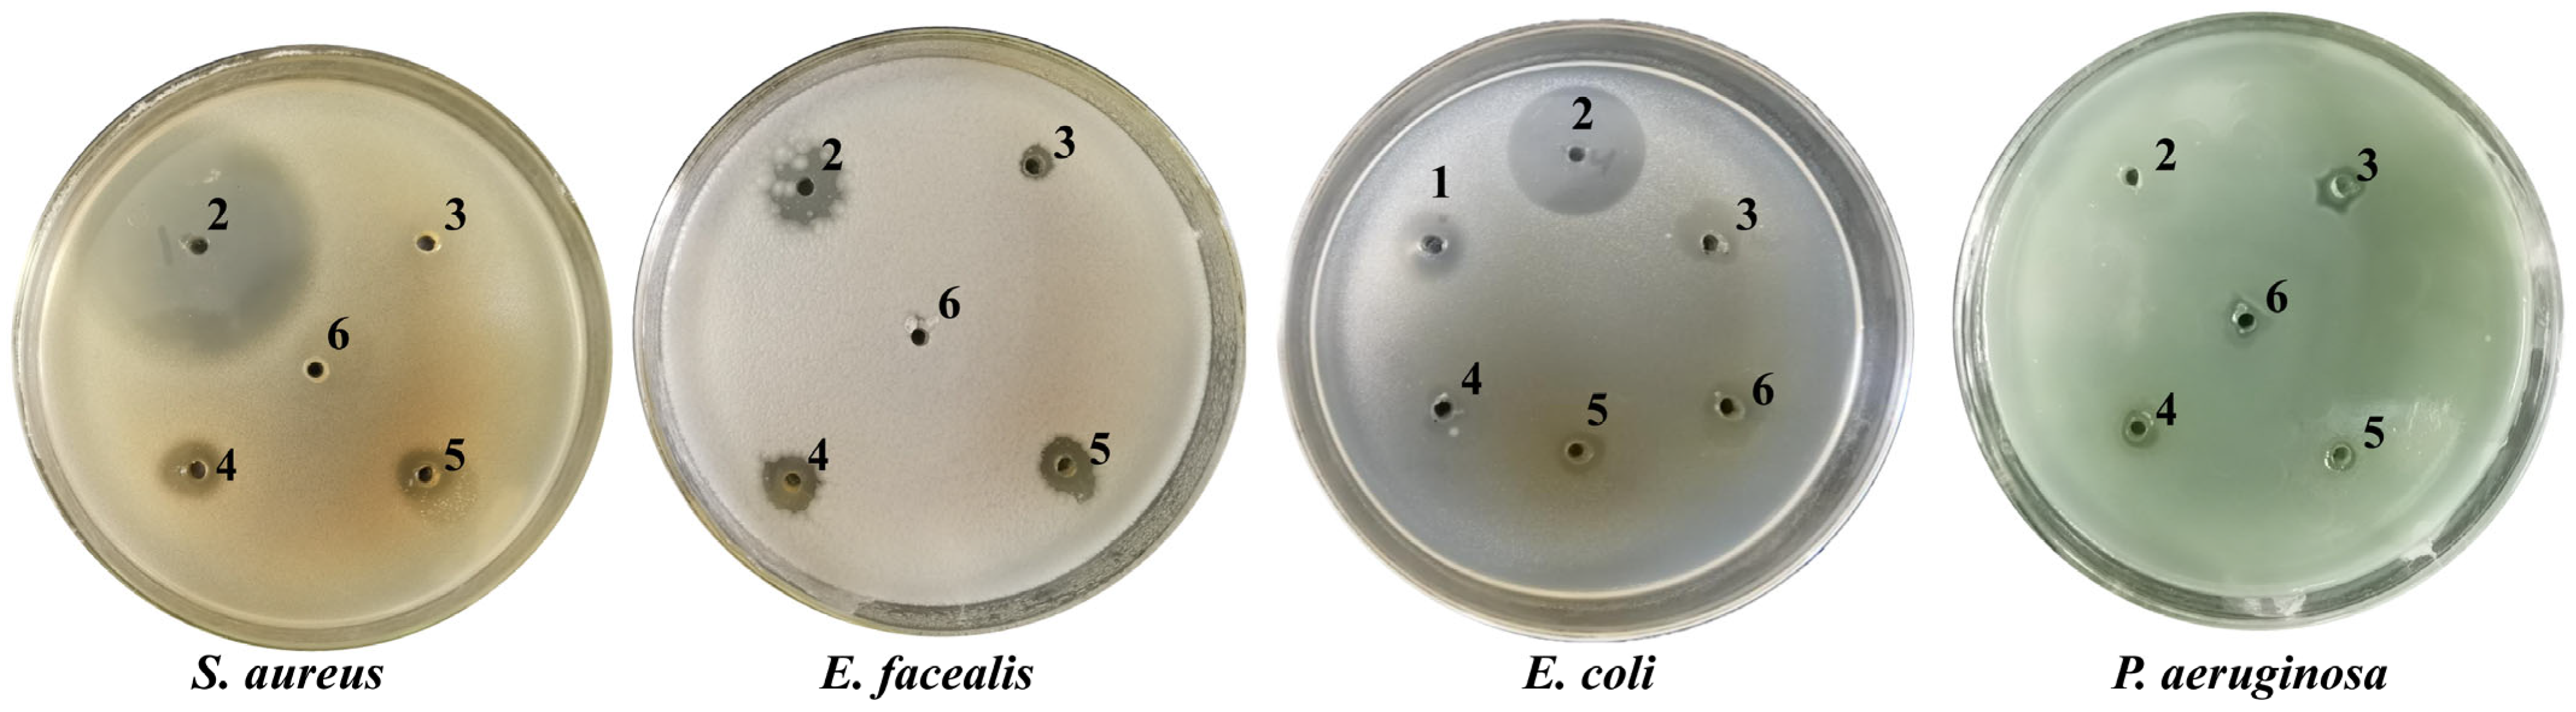
Separations 12 00294 g004 Separations 12 00294 g004

Abstract
Rosmarinic acid (RA), a natural polyphenolic hydroxyl compound found from plants, exhibits many biological activities. This study reported an efficient purification method for RA from the water-soluble rosemary extract. By employing silica gel column chromatography combined with liquid–liquid extraction, the water-soluble extract of rosemary was refined to yield RA with a purity of 92.85 ± 3.18%. To further enhance the potential of RA as a natural preservative, the prepared RA was esterified to produce methyl rosmarinate (RA-me) and propyl rosmarinate (RA-pro). The antioxidant and antibacterial activities of RA and its derivatives were subsequently evaluated. The results indicated that RA and its esterified derivatives exhibited more pronounced antibacterial efficacy against the Gram-positive bacteria than Gram-negative bacteria. Moreover, the antibacterial activity of the ester derivatives was enhanced compared to that of RA. RA and RA-me exhibited comparable antioxidant activity, which was superior to that of RA-pro. In summary, this study established an effective purification strategy for RA, laying a foundation for developing better natural, non-toxic preservatives with antibacterial activity.
1. Introduction
Preservatives serve to prevent spoilage and prolong the shelf life of food, cosmetics, and medications while maintaining their quality and safety. Antibacterial and antioxidant properties are two main characteristics of preservatives [1]. Although synthetic preservatives, such as butylated hydroxytoluene (BHT), benzoates, and butylated hydroxy anisole (BHA), have been widely used in the food industry for the protection of food due to their strong antibacterial and antioxidant properties, their safety remains controversial. Studies have indicated potential health risks associated with these compounds, including acute toxicity, carcinogenicity, teratogenicity, and environmental persistence due to slow decomposition [2]. Such concerns have accelerated the search for natural, safe, and effective alternatives capable of conferring comparable protection against microbial growth and oxidative deterioration.
Rosmarinic acid (RA), a common polyphenol found in plants belonging to the Lamiaceae family, is one of the most important components in rosemary (Rosmarinus officinalis), which has drawn significant attention as a multifunctional natural bioactive components [3]. As a highly effective antioxidant component in rosemary, RA is often used as a marker compound for quality assessment [4]. Beyond its well-established antioxidant capacity, RA exhibited a broad spectrum of biological activities, including antibacterial [5,6], antiviral [7,8], anti-cancer [9], anti-inflammatory [10,11], anti-diabetes [12], anti-allergic [13], anti-depressant, and neuroprotective [10,14]. As a natural antioxidant, it has better thermal stability and safety than other natural antioxidant components [15,16]. Therefore, the preparation of high-purity rosmarinic acid antioxidant will have high market development potential.
To enhance the antioxidant efficacy of rosemary extract and explore the biological activities of RA, various downstream processing methods have been applied to extract and purify this valuable compound. Molecularly imprinted solid-phase extraction and sequential chromatography using macroporous and polyamide resins, have been developed, achieving RA purity levels exceeding 80% [17]. However, many of these approaches remained confined to analytical scales, with limitations in cost-effectiveness and scalability hindering industrial application.
Recent research has demonstrated that RA derivatives, particularly esterified forms, exhibit enhanced biological activities compared to the parent compound. Zhu reported that esterification of RA with various alcohols significantly improved its antibacterial activity, with propyl (RA-pro) and hexyl (RA-hex) derivatives showing superior efficacy against Bacillus cereus compared to tannic acid, a well-known natural antibacterial agent [18]. These derivatives also exerted enhanced α-glucosidase inhibitory activity and lipid accumulation suppression properties, suggesting their potential multifunctional applications in food and pharmaceutical industries.
Previous research reported a method for the simultaneous preparation of both lipid- and water-soluble antioxidants from rosemary [4]. The water-soluble antioxidant extract contained 10.46% RA. Based on this, an effective method for producing high-purity RA (>92% purity) was established in this study. To further enhance the applicability of RA as a natural preservative, methyl RA (RA-me) and propyl RA (RA-pro) were prepared, and antibacterial and antioxidant activities of RA and its derivatives were compared. This study established a theoretical foundation for the broader use of RA and the advancement of superior natural and non-toxic preservatives.
2. Materials and Methods
2.1. Reagents and Materials
Our laboratory cultivated rosemary and the previously published procedures for RA extraction was prepared according to our previously method [4]. Burdick & Jackson (Muskegon, MI, USA) supplied the HPLC solvents, while Yuanye Biotechnology (Shanghai, China) provided the standard RA (purity 90%). Local vendors supplied the remaining food-grade and analytical solvents and reagents.
2.2. Purification of RA
A water-soluble rosemary extract containing 10.46% RA was utilized for purification purposes. The initial stage was dissolving the water-soluble extract in 50-fold excess water at varying pH levels (1, 2, 3, 4, 5, 6, 7). Following this, an equal volume of ethyl acetate was added for liquid–liquid extraction. After separating into two phases, the upper organic phase was collected and vacuum-dried to obtain powder for purity analysis.
RA was further purified using silica gel column chromatography (200–300 mesh, Sichuan Changwei Pharmaceutical Co., Ltd., Leshan, China). The powder was solubilized with ethyl acetate and introduced into a silica gel chromatography column. The isocratic elution was performed using ethyl acetate containing different concentrations of formic acid (0 to 2.5%), and the eluents were collected in bed volume (BV) units at a flow rate of 2 BV/h. HPLC was used to measure the RA concentrations in each BV to analyze the elution effect. Purified RA was obtained by vacuum drying.
2.3. Esterification of RA
The previously described procedure was followed for the esterification of RA [18]. RA was reacted with methanol and 1-propanol to synthesize RA-me and RA-pro, respectively (Figure 1).
Figure 1.
Structure of RA and its derivatives (drawn using ChemDraw2020).
RA-me was produced by dissolving 50 mg of RA in 2.07 mL of methanol with HCl (1%). After a day of the reaction at ambient temperature, the solution was diluted with 4.14 mL of water and extracted thrice using 4.14 mL of ether in a separating funnel. Following the addition of water, 5% NaHCO3, and saturated saline water, the ether solution was rinsed several times. To produce RA-me, the solution was vacuum-dried [18].
To produce RA-pro, 50 mg of RA was dissolved in 6.05 mL of 1-propanol with HCl (1%). After three days of the reaction being conducted at room temperature, the solution was diluted with 12.1 mL of water and extracted three times using 12.1 mL of ether in a separating funnel. The ether solution was combined and washed as described above. The solution was vacuum-dried to obtain RA-pro [18].
2.4. RA and Its Derivatives Analysis
2.4.1. HPLC Analysis
High-Performance Liquid Chromatography (HPLC) analysis was conducted using an Agilent 1260 series system (Agilent Technologies, Lexington, MA, USA) equipped with a DAD-3000 diode array detector. Separation was achieved on an Agilent ZORBAX Eclipse Plus C18 column (250 mm × 4.6 mm, 5 μm) maintained at 30 °C. The mobile phase consisted of a mixture of acetonitrile and 0.1% trifluoroacetic acid in water (40:60, v/v), which was delivered isocratically at a flow rate of 0.8 mL/min. The injection volume was 10 μL. The detection was carried out at a wavelength of 330 nm. Chromatographic peaks of RA was identified by comparing their retention times and UV-Vis spectra with RA standard, and its derivatives were identified using mass spectrometry (MS) analysis and Fourier-Transform infrared spectroscopy (FT-IR) compared to previously published data.
2.4.2. MS/MS Analysis
For further structural confirmation, mass spectrometry (MS) analysis was performed using an Agilent 7000D MS Triple Quad system (Agilent Technologies, Lexington, MA, USA). The ionization was carried out in negative electrospray ionization (ESI) mode. Full-scan data were acquired over a mass range of m/z 100 to 1000. The identities of RA derivatives were confirmed by comparing the observed molecular ion peaks [M-H]− and fragmentation patterns with literature values.
2.4.3. FT-IR Analysis
RA and its derivatives were analyzed by a Thermo Nicolet 6700 FT-IR spectroscopy (Thermo Fisher Scientific, Waltham, CA, USA). Scans were accumulated over a wavenumber range of 4000 to 400 cm−1 with a resolution of 4 cm−1. The characteristic absorption bands, particularly those for the hydroxyl (-OH), carbonyl (C=O), and aromatic (C=C) groups, were identified and compared with previously published FT-IR data for rosmarinic acid and related compounds to support structural identification.
2.5. Antibacterial Activity Assay
2.5.1. Disk Diffusion Assay
The method described by Rajitha was used to assess the antibacterial activity with slight modifications [19]. Antibacterial activity was conducted on four types of bacteria, including Gram-positive (Enterococcus faecalis and Staphylococcus aureus) and Gram-negative bacteria (Pseudomonas aeruginosa and Escherichia coli).
Using the plate streak technique, all the bacterial strains were grown on Muller-Hinton (MH) agar for 12–24 h at 37 °C. After that, one colony was moved from the culture medium to the MH liquid culture media, and it was incubated for 8 to 12 h at 37 °C on a shaker.
On the surface of MH agar, 75 μL of each culture was spread. Following this, 5 mm holes on the medium surface were filled with 20 μL of 0.1, 1, and 10 mg/mL RA extracts dissolved by ethanol. The inhibition zone width was measured to assess the antibacterial activity following a 12 h incubation at 37 °C. Using the same technique as a positive control, the antibacterial activity of 1 mg/mL ampicillin was determined, and ethanol as a negative control [4].
2.5.2. Determination of Minimum Inhibitory Concentration (MIC)
The broth dilution technique was used to estimate the minimal inhibitory concentration (MIC). The samples underwent a repeated two-fold dilution process on 96-well plates using liquid culture media. The final concentration of the sample solution ranged from 1.5625 × 10−2 to 4 mg/mL. After the bacteria were inoculated, the plates were incubated for 18 h at 37 °C. MTT was added to evaluate the presence of live cells. The appearance of purple precipitates indicated the presence of live cells. Moreover, the lack of purple precipitates demonstrated the complete inhibition of bacterial growth. The MIC value was established as the lowest concentration of the sample solution capable of completely inhibiting bacterial growth.
2.6. Antioxidant Activity Assay
2.6.1. Radical Scavenging Assay
The radical scavenging examination is widely utilized for the preliminary screening of antioxidant capacity based on the ability of test compounds to donate hydrogen atoms and neutralize stable DPPH radicals, which was conducted using the methodology Brand Williams described previously [20]. The samples were prepared as 3.125, 6.25, 12.5, 25, 50, 100, and 200 μg/mL, using ethanol as the solvent. In each well of a 96-well plate, 100 μL of the sample solution and 100 μL of DPPH solution (0.1 mmol/L prepared in ethanol) were combined. After 30 min of incubation in the dark at the ambient temperature, the absorbance of the solution was detected using a multifunctional enzyme marker at 517 nm. The same technique was used to test ascorbic acid’s (Vc) capacity to scavenge free radicals as a positive control.
2.6.2. Ferric Reducing Antioxidant Power Assay
The ferric reducing antioxidant power (FRAP) assay was conducted to evaluate the reducing capacity of the samples, following the original methodology developed by Benzie and Strain [21]. Freshly prepared in a volume ratio of 10:1:1, the FRAP working solution contained 300 mmol/L sodium acetate buffer (pH = 3.6), 10 mmol/L TPTZ solution (consisting of 40 mmol/L HCl solution), and 20 mmol/L FeCl3 solution. The samples were prepared as 3.125, 6.25, 12.5, 25, 50, 100, and 200 μg/mL, using ethanol as the solvent. For detection, the sample solution (0.3 mL) was added to FRAP working solution (2.7 mL) and incubated for 10 min at 37 °C before measuring the absorbance at 593 nm. Using the identical procedure as a positive control, the reducing power of ascorbic acid (Vc) was determined.
2.7. Statistical Analysis
At least three replications of each experiment were conducted. Each replication belonged to a different batch, and the results were the average of three or more independent repeats ± standard errors. Data analysis was done using SPSS (version 18.0 demo; SPSS, Armonk, NY, USA). For experiments yielding a significant F-value, pairwise comparisons were performed using Tukey’s post hoc test. A p-value of less than 0.05 was considered statistically significant.
3. Results and Discussion
3.1. Rosmarinic Acid Purification
A water-soluble rosemary extract with an RA content of 10.46% served as the starting material for purification [4]. To optimize the liquid–liquid extraction of RA into ethyl acetate, the extract was dissolved in aqueous solutions adjusted to different pH values. Figure 2A demonstrated that the extraction efficiency was highly dependent on pH, increasing substantially as the pH decreased, with the highest efficiency achieved between pH 1 and 2. The extraction rate could reach 64.05 ± 0.04% in a single step at pH 2. The extraction rate could further reach 93.08 ± 0.2% after extracting three times (Figure 2B). The purity of RA powder was 48.38 ± 0.31% after solvent removal.
Figure 2.
Effect of water pH on the extraction of RA by ethyl acetate (A), determination of extraction times of ethyl acetate (B), results of ethyl acetate elution of RA (C), and purification of RA by silica gel column chromatography with different proportions of ethyl acetate and formate (D). Lowercase letters represent significant differences in each treatment (p < 0.05).
Subsequently, RA underwent further purification by silica gel column chromatography using isocratic ethyl acetate as the elution solvent. As shown in Figure 2C, RA was concentrated and eluted at the fifth bed volume (BV), yielding a recovery of 54.5 ± 8.48%. The eluent conditions were further optimized due to the acidic properties of RA. Figure 2D indicated that RA’s purity and recovery rate achieved optimal levels in ethyl acetate containing 1.5% formic acid. The recovery rate and purity of RA were 90.80 ± 2.73% and 92.85 ± 3.18%, respectively. In a previous study, Zhang purified RA using NK-109 resin and obtained 42.1% purity of RA [22]. Tang separated the 50% ethanol extract of Perilla using a column chromatography technique that included macroporous resin and polyamide resin, raising the RA concentration from 0.27% to 16.58%. After further purification, the purity of RA in the 70% ethanol component was 90.23% [23]. This study exhibited a more efficient preparation method combining liquid–liquid extraction and isocratic silica gel column chromatography to get RA with purity over 90%, conserving solvents and reducing expenses while facilitating research on the physiological functions and commercial applications of RA.
3.2. Preparation and Characterization of RA Derivatives
RA with a purity over 90% was esterified via an acid-catalyzed method [18]. The HPLC profile of the prepared RA was identical to that of the standard RA. (Figure 3A,B). Following the esterification reaction, HPLC analysis revealed a single peak for RA-me at 11.369 min, and RA-pro appeared at 23.503 min. Moreover, a very low concentration of RA was detected in RA-me and RA-pro, signifying a comprehensive reaction (Figure 3C,D). The respective HPLC fractions of RA-me and RA-pro were collected and subjected to Q-TOF-MS/MS analysis. As shown in Figure 3E, the deprotonated molecule [M-H]− of RA-me was observed at m/z 373.0917, with characteristic fragment ions at m/z 135.0448, 161.0232, 179.0348, and 193.0497, consistent with literature values [24]. Similarly, RA-pro exhibited a [M-H]− ion at m/z 401.1201 and a fragmentation pattern that also matched published data (Figure 3F).
Figure 3.
Characterization of RA and its derivatives. HPLC analysis of standard RA (A), RA purified product (B), RA-me (C), and RA-pro (D). MS/MS spectra of RA-me (E) and RA-pro (F). Infrared spectra of RA and its derivatives (G).
The recorded infrared spectrum of RA was consistent with the previously reported result [25], as shown in Figure 3G. The recorded spectral bands of RA were observed between 4000–700 cm−1, with the primary features located in the 1800–700 cm−1. The broad band at 3650–3200 cm−1 is attributed to O-H stretching vibrations. A noticeable reduction in the intensity of this band was observed for RA-me and RA-pro compared to RA. This can be explained by the esterification reaction, in which the carboxylic acid group of RA reacts with the hydroxyl group of the alcohol, forming an ester and releasing water as a byproduct. Characteristic bands for carboxylic acid groups were observed in the 1725–1700 cm−1 region. In the presence of aromatic systems, the absorption band of the carboxylic acid group, as well as that of the resulting ester (typically observed at 1750–1725 cm−1), may shift to wavenumbers below 1700 cm−1. Therefore, the absorption band near 1685 cm−1 may be assigned to these functional groups, as previously suggested [25]. Compared to RA, the intensity of this band around 1685 cm−1 decreased for both RA-me and RA-pro. Additionally, C-H stretching vibrations of saturated carbon atoms appeared in the 3000–2700 cm−1 region, where RA-pro, containing more C-H bonds, exhibited higher absorption intensity than RA-me.
3.3. Antibacterial Activity Assay of RA and Its Derivatives
Antibiotics, one of the most pivotal medical breakthroughs of the past century, have been widely employed in treating infectious diseases in humans and animals. However, antimicrobial resistance has emerged as a global danger to public health due to its extensive overutilization in the medical and agricultural sectors [26]. This challenge has intensified the demand for novel antibacterial agents in both healthcare and agricultural food industries. To evaluate the antibacterial activity of RA, two common Gram-positive and two common Gram-negative bacteria were selected. As shown in Figure 4, ampicillin was used as the positive control, and solvent ethanol was used as the negative control. RA exhibited significant antibacterial effects against the two Gram-positive bacteria S. aureus and E. faecalis at high doses (10 mg/mL and 20 mg/mL). The inhibitory zone diameters of RA against were 1.35 cm and 0.90 cm, respectively, at a dose of 10 mg/mL. At low doses (1 mg/mL), RA had no significant antibacterial efficacy against S. aureus, although it exhibited mild antibacterial action against E. faecalis. RA had only modest antibacterial activity against the Gram-negative bacteria E. coli and P. aeruginosa, with inhibitory zones measuring just 0.7 cm even at a high dosage of 20 mg/mL. This observed disparity is commonly attributed to the structural differences in bacterial cell envelopes. The outer membrane of Gram-negative bacteria, rich in lipopolysaccharides (LPS), presents a formidable permeability barrier to many hydrophobic compounds like RA, restricting its entry into the cell [27]. Additionally, efflux pumps in Gram-negative species further contribute to intrinsic resistance by expelling antimicrobial agents [28]. Overall, these results indicated that RA exhibited stronger antibacterial efficacy against Gram-positive bacteria than against Gram-negative strains. However, its overall antibacterial performance remains insufficient to replace conventional synthetic antibiotics.
Figure 4.
Antibacterial effects of RA against four typical bacteria. (1) 0.1 mg/mL ampicillin, (2) 1 mg/mL ampicillin, (3) 1 mg/mL RA, (4) 10 mg/mL RA, (5) 20 mg/mL RA, (6) ethanol.
To enhance the antibacterial activity of RA, the antibacterial activity of its derivatives were further evaluated. With minimum inhibitory concentration (MIC) values of 0.5 mg/mL and 1 mg/mL for S. aureus and E. coli, respectively, RA-me and RA-pro exhibited superior antibacterial activity than RA (Table 1), which was consistent with other research on the antibacterial activity of RA esterified derivatives [18,29]. As a phenolic compound, RA exerted its antibacterial activity mainly through the inactivation of cellular enzymes [30], which largely depended on its cellular penetration rate and ability to alter membrane permeability. Esterification modification increased the hydrophobicity of RA, thereby enhancing its permeability through bacterial cell membranes and ultimately improving its antibacterial efficacy.
Table 1.
MIC results of RA and its derivatives.
3.4. Antioxidant Activity Assay of RA and Its Derivatives
RA is one of rosemary’s primary antioxidant constituents. The DPPH and FRAP assays were used to quantify the antioxidant activity of RA and its derivatives to assess the effect of esterification on antioxidant activity. The DPPH assay demonstrated that RA and its derivatives exhibited a concentration-dependent relationship with the free radical scavenging rate, wherein increased concentrations resulted in elevated scavenging rates (Figure 5A). At low concentrations (<12.5 μg/mL), RA exhibited a linearly increased antioxidant activity, had stronger antioxidant activity than Vc, and also exhibited superiority over RA-me and RA-pro. At higher concentrations (≥50 μg/mL), the antioxidant activity of RA reached saturation, which was equivalent to that of VC, and much stronger than RA-pro (50.69% at 200 μg/mL). Previous studies indicated that RA had superior antioxidant activity compared to butyl hydroxyanisole, suggesting its significant potential as a substitute for chemically synthesized antioxidants [31]. The results suggested that esterification led to a reduction in antioxidant activity.
Figure 5.
Antioxidant activity assay of RA and its derivatives using DPPH method (A) and FRAP method (B). Lowercase letters represent significant differences in each treatment (p < 0.05).
Similar trends were observed in the FRAP assay, as shown in Figure 5B. The FRAP values of RA and its derivatives were concentration dependent. At a dose of 200 μg/mL, the FRAP values for RA, RA-me, and RA-pro were 1.88 mmol/L, 1.72 mmol/L, and 0.61 mmol/L, respectively. The FRAP value of RA was much higher than that of RA-pro, which was consistent with the reported research results that the free radical scavenging ability of esterified RA derivatives decreased [32]. Previous studies have shown that the amount of -OH could affected the antioxidant activity of phenolic acids [33]. The reduction in antioxidant activity following esterification might result from the elimination of hydroxyl groups on the carboxyl group and a reduced number of hydroxyl groups post-esterification of RA. The difference in antioxidant activity between RA-me and RA was not significant. Moreover, in cell-based assays, RA-me showed better efficacy [34], suggesting that RA-me might have greater potential for medicinal applications.
4. Conclusions
In this study, an efficient purification method was developed to isolate RA from water-soluble rosemary extract. After the water-soluble rosemary extract was first dissolved in acidified water (pH = 2), and then subjected to triple extraction using an equal volume of ethyl acetate. The resulting extract was further purified by silica gel column chromatography, eluting with an isocratic ethyl acetate solution containing 1.5% formic acid. Through this procedure, RA was obtained with a purity of 92.85 ± 3.18%. The purified RA was subsequently esterified to yield RA-me and RA-pro, and the antioxidant and antibacterial activities of these derivatives were evaluated and compared with those of RA. Esterified derivatives of RA exhibited superior antibacterial properties compared to RA alone. They demonstrated greater efficacy against Gram-positive bacteria compared to Gram-negative bacteria. Furthermore, RA and RA-me exhibited comparable antioxidant activity, surpassing that of RA-pro. This study established an efficient method for preparing high-purity RA from rosemary extract. The methylated derivative RA-me exhibited promising antibacterial and antioxidant properties, highlighting its potential as a natural preservative for applications in the food and pharmaceutical industries.
Author Contributions
Conceptualization, A.-J.C. and C.-J.M.; methodology, A.-J.C.; software, J.L.; validation, A.-J.C., Y.F. and C.-J.M.; formal analysis, Y.F.; investigation, C.-J.M.; resources, C.-W.Y.; data curation, J.L.; writing—original draft preparation, A.-J.C.; writing—review and editing, A.-J.C.; visualization, J.L.; supervision, C.-W.Y.; project administration, H.N.; funding acquisition, H.N. All authors have read and agreed to the published version of the manuscript.
Funding
This research received no external funding.
Data Availability Statement
The original contributions presented in this study are included in the article. Further inquiries can be directed to the corresponding author.
Conflicts of Interest
The authors declare no conflicts of interest.
References
- Yarraguntla, S.R.; Kamala Kumari, P. Alternative to Artificial Preservatives. Syst. Rev. Pharm. 2019, 10, 99–102. [Google Scholar]
- Novais, C.; Molina, A.K.; Abreu, R.M.V.; Santo-Buelga, C.; Ferreira, I.; Pereira, C.; Barros, L. Natural Food Colorants and Preservatives: A Review, a Demand, and a Challenge. J. Agric. Food Chem. 2022, 70, 2789–2805. [Google Scholar] [CrossRef]
- Marchev, A.S.; Vasileva, L.V.; Amirova, K.M.; Savova, M.S.; Koycheva, I.K.; Balcheva-Sivenova, Z.P.; Vasileva, S.M.; Georgiev, M.I. Rosmarinic acid—From bench to valuable applications in food industry. Trends Food Sci. Technol. 2021, 117, 182–193. [Google Scholar] [CrossRef]
- Mo, C.-J.; Xu, Y.-Q.; Feng, Y.; Chen, A.-J.; Yang, C.-W.; Ni, H. Simultaneous preparation of water- and lipid-soluble antioxidant and antibacterial activity of purified carnosic acid from Rosmarinus offoccnalis L. Ind. Crops Prod. 2022, 187, 115448. [Google Scholar] [CrossRef]
- Zhang, J.; Cui, X.; Zhang, M.; Bai, B.; Yang, Y.; Fan, S. The antibacterial mechanism of perilla rosmarinic acid. Biotechnol. Appl. Biochem. 2022, 69, 1757–1764. [Google Scholar] [CrossRef]
- Kernou, O.N.; Azzouz, Z.; Madani, K.; Rijo, P. Application of Rosmarinic Acid with Its Derivatives in the Treatment of Microbial Pathogens. Molecules 2023, 28, 4243. [Google Scholar] [CrossRef] [PubMed]
- Makhathini, K.B.; Mabandla, M.V.; Daniels, W.M.U. Rosmarinic acid reverses the deleterious effects of repetitive stress and tat protein. Behav. Brain Res. 2018, 353, 203–209. [Google Scholar] [CrossRef]
- Tsukamoto, Y.; Ikeda, S.; Uwai, K.; Taguchi, R.; Chayama, K.; Sakaguchi, T.; Narita, R.; Yao, W.L.; Takeuchi, F.; Otakaki, Y.; et al. Rosmarinic acid is a novel inhibitor for Hepatitis B virus replication targeting viral epsilon RNA-polymerase interaction. PLoS ONE 2018, 13, e0197664. [Google Scholar] [CrossRef]
- Liu, T.; Sui, X.; Zhang, R.; Yang, L.; Zu, Y.; Zhang, L.; Zhang, Y.; Zhang, Z. Application of ionic liquids based microwave-assisted simultaneous extraction of carnosic acid, rosmarinic acid and essential oil from Rosmarinus officinalis. J. Chromatogr. A 2011, 1218, 8480–8489. [Google Scholar] [CrossRef]
- Dahchour, A. Anxiolytic and antidepressive potentials of rosmarinic acid: A review with a focus on antioxidant and anti-inflammatory effects. Pharmacol. Res. 2022, 184, 106421. [Google Scholar] [CrossRef]
- Luo, C.; Zou, L.; Sun, H.; Peng, J.; Gao, C.; Bao, L.; Ji, R.; Jin, Y.; Sun, S. A Review of the Anti-Inflammatory Effects of Rosmarinic Acid on Inflammatory Diseases. Front. Pharmacol. 2020, 11, 153. [Google Scholar] [CrossRef]
- Ngo, Y.L.; Lau, C.H.; Chua, L.S. Review on rosmarinic acid extraction, fractionation and its anti-diabetic potential. Food Chem. Toxicol. 2018, 121, 687–700. [Google Scholar] [CrossRef]
- Zhu, F.; Asada, T.; Sato, A.; Koi, Y.; Nishiwaki, H.; Tamura, H. Rosmarinic acid extract for antioxidant, antiallergic, and α-glucosidase inhibitory activities, isolated by supramolecular technique and solvent extraction from Perilla leaves. J. Agric. Food Chem. 2014, 62, 885–892. [Google Scholar] [CrossRef]
- Ghasemzadeh Rahbardar, M.; Hosseinzadeh, H. Effects of rosmarinic acid on nervous system disorders: An updated review. Naunyn Schmiedebergs Arch. Pharmacol. 2020, 393, 1779–1795. [Google Scholar] [CrossRef]
- Mallegni, N.; Cicogna, F.; Passaglia, E.; Gigante, V.; Coltelli, M.; Coiai, S. Natural Antioxidants: Advancing Stability and Performance in Sustainable Biobased and Biodegradable Plastics. Compounds 2025, 5, 4. [Google Scholar] [CrossRef]
- Dziadek, K.; Kopeć, A.; Dziadek, M.; Sadowska, U.; Cholewa-Kowalska, K. The Changes in Bioactive Compounds and Antioxidant Activity of Chia (Salvia hispanica L.) Herb under Storage and Different Drying Conditions: A Comparison with Other Species of Sage. Molecules 2022, 27, 1569. [Google Scholar] [CrossRef]
- Saad, E.M.; El Gohary, N.A.; Abdel-Halim, M.; Handoussa, H.; El Nashar, R.M.; Mizaikoff, B. Molecularly imprinted polymers for selective extraction of rosmarinic acid from Rosmarinus officinalis L. Food Chem. 2021, 335, 127644. [Google Scholar] [CrossRef]
- Zhu, F.; Wang, J.; Takano, H.; Xu, Z.; Nishiwaki, H.; Yonekura, L.; Yang, R.; Tamura, H. Rosmarinic acid and its ester derivatives for enhancing antibacterial, α-glucosidase inhibitory, and lipid accumulation suppression activities. J. Food Biochem. 2019, 43, e12719. [Google Scholar] [CrossRef]
- Rajitha, G.; Ravibabu, V.; Ramesh, G.; Rajitha, B.; Jobina, R.; Siddhardha, B.; Vijaya Laxmi, S. One-pot multicomponent synthesis of novel thiazolylhydrazone derivatives and their antimicrobial activity. Res. Chem. Intermed. 2015, 41, 9703–9713. [Google Scholar] [CrossRef]
- Brand-Williams, W.; Cuvelier, M.E.; Berset, C. Use of a free radical method to evaluate antioxidant activity. LWT Food Sci. Technol. 1995, 28, 25–30. [Google Scholar] [CrossRef]
- Benzie, I.F.; Strain, J.J. The ferric reducing ability of plasma (FRAP) as a measure of antioxidant power: The FRAP assay. Anal. Biochem. 1996, 239, 70–76. [Google Scholar] [CrossRef] [PubMed]
- Zhang, J.H.; Zhang, M.; Bai, B.Q.; Jia, H.W.; Fan, S.H. Studies on Adsorption Kinetics and Thermodynamics of Macroporous Resin for Rosmarinic Acid. J. Oleo Sci. 2021, 70, 439–451. [Google Scholar] [CrossRef]
- Tang, W.; Sun, B.; Zhao, Y. Preparative separation and purification of rosmarinic acid from perilla seed meal via combined column chromatography. J. Chromatogr. B 2014, 947, 41–48. [Google Scholar] [CrossRef]
- Contreras, M.d.M.; Algieri, F.; Nogales, A.; Galvez, J.; Segura Carretero, A. Phytochemical profiling of anti-inflammatory Lavandula extracts via RP-HPLC-DAD-QTOF-MS and -MS/MS: Assessment of their qualitative and quantitative differences. Electrophoresis 2017, 39, 1284–1293. [Google Scholar] [CrossRef]
- Stehfest, K.; Boese, M.; Kerns, G.; Piry, A.; Wilhelm, C. Fourier transform infrared spectroscopy as a new tool to determine rosmarinic acid in situ. J. Plant Physiol. 2004, 161, 151–156. [Google Scholar] [CrossRef]
- Ferri, M.; Ranucci, E.; Romagnoli, P.; Giaccone, V. Antimicrobial resistance: A global emerging threat to public health systems. Crit. Rev. Food Sci. Nutr. 2017, 57, 2857–2876. [Google Scholar] [CrossRef]
- Nikaido, H. Molecular basis of bacterial outer membrane permeability revisited. Microbiol. Mol. Biol. Rev. 2003, 67, 593–656. [Google Scholar] [CrossRef]
- Li, X.Z.; Plésiat, P.; Nikaido, H. The challenge of efflux-mediated antibiotic resistance in Gram-negative bacteria. Clin. Microbiol. Rev. 2015, 28, 337–418. [Google Scholar] [CrossRef]
- Abedini, A.; Roumy, V.; Mahieux, S.; Biabiany, M.; Standaert-Vitse, A.; Rivière, C.; Sahpaz, S.; Bailleul, F.; Neut, C.; Hennebelle, T. Rosmarinic Acid and Its Methyl Ester as Antimicrobial Components of the Hydromethanolic Extract of Hyptis atrorubens Poit. (Lamiaceae). Evid. Based Complement. Altern. Med. 2013, 2013, 604536. [Google Scholar] [CrossRef] [PubMed]
- Ekambaram, S.P.; Perumal, S.S.; Balakrishnan, A.; Marappan, N.; Gajendran, S.S.; Viswanathan, V. Antibacterial synergy between rosmarinic acid and antibiotics against methicillin-resistant Staphylococcus aureus. J. Intercult. Ethnopharmacol. 2016, 5, 358–363. [Google Scholar] [CrossRef] [PubMed]
- Al-Musayeib, N.; Perveen, S.; Fatima, I.; Nasir, M.; Hussain, A. Antioxidant, anti-glycation and anti-inflammatory activities of phenolic constituents from Cordia sinensis. Molecules 2011, 16, 10214–10226. [Google Scholar] [CrossRef]
- Lecomte, J.; Giraldo, L.J.L.; Laguerre, M.; Baréa, B.; Villeneuve, P. Synthesis, Characterization and Free Radical Scavenging Properties of Rosmarinic Acid Fatty Esters. J. Am. Oil Chem. Soc. 2010, 87, 615–620. [Google Scholar] [CrossRef]
- Sroka, Z.; Cisowski, W. Hydrogen peroxide scavenging, antioxidant and anti-radical activity of some phenolic acids. Food Chem. Toxicol. 2003, 41, 753–758. [Google Scholar] [CrossRef] [PubMed]
- Adomako-Bonsu, A.G.; Chan, S.L.; Pratten, M.; Fry, J.R. Antioxidant activity of rosmarinic acid and its principal metabolites in chemical and cellular systems: Importance of physico-chemical characteristics. Toxicol. In Vitr. 2017, 40, 248–255. [Google Scholar] [CrossRef] [PubMed]
Disclaimer/Publisher’s Note: The statements, opinions and data contained in all publications are solely those of the individual author(s) and contributor(s) and not of MDPI and/or the editor(s). MDPI and/or the editor(s) disclaim responsibility for any injury to people or property resulting from any ideas, methods, instructions or products referred to in the content. |
© 2025 by the authors. Licensee MDPI, Basel, Switzerland. This article is an open access article distributed under the terms and conditions of the Creative Commons Attribution (CC BY) license (https://creativecommons.org/licenses/by/4.0/).